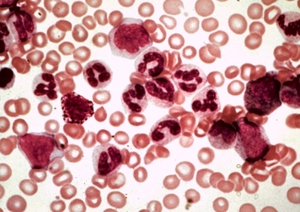

Чи можна пити молоко при лейкозі у корів?
 Лейкоз у корів – це хронічне, тривала хвороба, що вражає кровотворну систему. Імунітету до цього розповсюдженому захворюванню тварини не мають, що призводить до частих спалахів в фермерських господарствах. Викликають його віруси лейкозу ВРХ. У зв'язку з недавніми дослідженнями, стало відомо, що лейкоз корів – це небезпечне захворювання, яке передається і впливає на людський організм.
Лейкоз у корів – це хронічне, тривала хвороба, що вражає кровотворну систему. Імунітету до цього розповсюдженому захворюванню тварини не мають, що призводить до частих спалахів в фермерських господарствах. Викликають його віруси лейкозу ВРХ. У зв'язку з недавніми дослідженнями, стало відомо, що лейкоз корів – це небезпечне захворювання, яке передається і впливає на людський організм.
Лейкоз корів: симптоми і причини
Дуже довго симптоми не проявляються. Хвора корова може не давати ніяких ознак. При цьому навіть може бути дуже продуктивна і народжувати здорових телят. Зараження відбувається через контакт хворої тварини зі здоровим. Шляхи передачі:
- Утробі матері. Дуже рідкісний випадок, але можливий. Вчені довели, що існує ймовірність отримати захворювання в 5-10% випадків.
- Кровоссальні комахи також можуть переносити вірус.
- Через бичаче насіння.
- При використанні прибирального інвентарю та інше.
Науково доведено 2 виду:
Спорадичний. Захворювання вражає молоді тварини до 3 років. Зустрічається рідко.
Спорадичний. Захворювання вражає молоді тварини до 3 років. Зустрічається рідко.- Ензоотична. Найбільш поширений вид. Зустрічає у дорослих корів і биків, з тривалим прихованим періодом симптомів, який виявляється тільки після здачі аналізу.
Симптоми часто виявляються на запущеній стадії. До основних ознаками відносять:
- Зменшення удою і продуктивності.
- Лімфовузли збільшені.
- Збільшення селезінки.
- Зниження ваги.
- Низький імунітет.
Як правило, після розтину хворої тварини спостерігаються численні пухлини. Вживати в м'ясо такий продукт ні в якому разі не можна, його потрібно негайно утилізувати.
Чи можна пити молоко? Вживання продуктів від хворої тварини, будь це м'ясо або молоко, призводить до ракових захворювань у людини. Допускається лише випоювання молодняку або інших тварин. При цьому слід прокип'ятити молоко протягом тривалого часу. Але не можна пити молоко навіть після кип'ятіння людям.
На ранній стадії без аналізу неможливо розпізнати хвору особину. Вона також може бути високоудійних, приносити здорових телят, не втрачати ваги. Незважаючи на це, вони несуть в собі небезпеку зараження для інших. В результаті може заразитися все стадо, що призведе до неминучих втрат. Інкубаційний період триває від 2 до 6 років. Народились телята хоч і є споконвічно здоровими, Входять до групи ризику в першу чергу. Також, можливо, зараження при випоюванні теляти молоком хворої матері.
Лейкоз у ВРХ: стадії розвитку хвороби
Хоч симптоматично хвороба себе практично ніяк не проявляє, але певні стадії все-таки є. Виділяють кілька:
 передлейкозною. Виявляється аналізами: серологічні (РІД) і вірусологічні.
передлейкозною. Виявляється аналізами: серологічні (РІД) і вірусологічні.- Початкова. При аналізах виявляється розвиток хворих клітин, а також збільшення лімфоцитів і лейкоцитів.
- розгорнута. На цій стадії захворювання починає проявляти себе за зовнішніми ознаками. Це може бути погіршення самопочуття, спад надоїв і продуктивності, гематологічні зміни.
- термінальна. Це остання стадія, яка має явні зовнішні ознаки і призводить до смерті.
діагностика
Виявити лейкоз у корів можна тільки за допомогою аналізів крові, особливо на початкових етапах. Діагностування проводять 2 методами:
 РІД. Аналіз беруть у всіх корів, старше півроку. Період прийому через 15 днів після щеплення туберкульозу, до отелення і після нього. Хворими коровами вважаються ті, у яких аналіз дав позитивний результат.
РІД. Аналіз беруть у всіх корів, старше півроку. Період прийому через 15 днів після щеплення туберкульозу, до отелення і після нього. Хворими коровами вважаються ті, у яких аналіз дав позитивний результат.- гематологічний. При цьому методі ведеться підрахунок лімфоцитів. При взятті аналізу кров необхідно досліджувати протягом 36 годин з моменту забору. Якщо позитивний результат, то потрібна повторна здача крові через 1 або 2 місяці.Другий раз може дати негативний результат і цього не завжди підтверджує помилку. Можливо, що це лише період ремісії. А через деякий час лімфоцити з новою силою почнуть зростати.
Навіть маючи 2 варіанти діагностики лейкозу у корів, є нюанси. При позитивних РІД тварина вважається вірусоносієм, але клінічно діагноз не ставиться. Потрібно робити повторний аналіз. Якщо РІД негативний, ато гемалогіческій позитивний, то діагностику проводять 2 раз. При позитивному результаті в обох випадках, необхідно піддати ліквідації тварина. Якщо РІД завжди дає негативний результат, то корову можна вважати здоровою.
Лейкоз у корів: заходи профілактики та лікування
Подібне захворювання прирівнюють до СНІДу. Все через те, що вірус захоплює лімфоцити. Знищуючи хвороботворні клітини, знищуються і лімфоцити. Це призводить до повного імунодефіциту. Вже не перше десятиліття вчені б'ються над вакциною, але поки результату не було і лейкоз у корів вважається невиліковним, Небезпечним захворюванням.
Будь-якому фермерському господарству важлива репутація. Отже, якщо більше 2 тварин мають позитивні результати на лейкоз, то можна вважати таке господарство неблагополучним. Така ситуація вимагає негайного вирішення. Ветеринарні служби можуть закрити підприємство на деякий час або дати можливість в короткий час вирішити проблему з хворими коровами. Складають обмежувальні заходи і розробляють план по ліквідації, оздоровлення всього стада.
Які приписуються обмежувальні заходи? В першу чергу забороняють утримувати хворих корів зі здоровими. зазвичай підприємства приймають рішення про забій хворого ВРХ. По-друге, забороняється використовувати і реалізовувати коров'яче молоко від хворих тварин. По-третє, ветеринарні служби стежать за тим, щоб лейкозні корови не знаходилися поблизу населених пунктів.
Щоб не допустити поширення вірусу, необхідно повністю позбутися від цього хворого поголів'я і проводити спеціальні заходи профілактики та дезінфекції. Не варто залишати корову тільки тому, що вона дає хороші надої і приносить хороших, здорових телят. В підсумку зараження піддадуться і інші тварини. Лейкоз у корів може швидко поширюватися і в подальшому підприємство зазнає великих збитків. Ветеринарна служба має право закрити підприємство, на якому неодноразово з'являються спалахи лейкозу. Є спеціальні програми з оздоровлення.
оздоровлення
У Європі вже давно вжили всіх необхідних заходів з оздоровлення ВРХ на урядовому рівні. Існують спеціальні програми, які дозволили повністю або частково усунути проблему. У таких країнах не спостерігається різких і сильних вогнищ захворювання на лейкоз. В даний час в Росії є один план оздоровлення:
- Підприємство дотримується норм карантину.
- Поступово або відразу ліквідує хворе господарство.
- Проводить заміну на здорове поголів'я.
 При цьому слід приділити особливу увагу до третього пункту. Якщо підприємство має можливість, то оздоровлення корів можна проводити, закуповуючи молодняк у європейських фермерських господарств. Щоб не допустити появу лейкозу, слід постійно оновлювати ВРХ, змінюючи їх родовід. Також слід, проводить заходи по профілактиці. А точніше, здійснювати якомога частіше діагностику своїх тварин. Якщо вийде вчасно виявити хвору тварину, то існує можливість запобігти поширенню.
При цьому слід приділити особливу увагу до третього пункту. Якщо підприємство має можливість, то оздоровлення корів можна проводити, закуповуючи молодняк у європейських фермерських господарств. Щоб не допустити появу лейкозу, слід постійно оновлювати ВРХ, змінюючи їх родовід. Також слід, проводить заходи по профілактиці. А точніше, здійснювати якомога частіше діагностику своїх тварин. Якщо вийде вчасно виявити хвору тварину, то існує можливість запобігти поширенню.
Висновок: цікаві факти
До сих пір ще не знайшли ліки, яке змогло б вилікувати лейкоз, але при цьому вчені виявили деякі цікаві факти. Захворювання боїться високої температури. При нагріванні в 60 градусів він помре протягом 3 хвилин, а при 100 він не протримається і пари секунд. Боротися з ним також можна і за допомогою цілком звичайних препаратів. Це їдкий натр (2-3%), формальдегід і хлор 3%.
